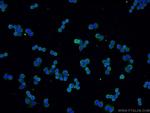
VCP Antibody in Immunocytochemistry (ICC/IF)

Search
Proteintech
VCP Monoclonal Antibody (2A4B10)
{{$productOrderCtrl.translations['antibody.pdp.commerceCard.promotion.promotions']}}
{{$productOrderCtrl.translations['antibody.pdp.commerceCard.promotion.viewpromo']}}
{{$productOrderCtrl.translations['antibody.pdp.commerceCard.promotion.promocode']}}: {{promo.promoCode}} {{promo.promoTitle}} {{promo.promoDescription}}. {{$productOrderCtrl.translations['antibody.pdp.commerceCard.promotion.learnmore']}}
产品信息
60316-1-IG
种属反应
宿主/亚型
分类
类型
克隆号
抗原
偶联物
形式
浓度
规格
纯化类型
保存液
内含物
保存条件
运输条件
产品详细信息
Immunogen sequence: GMTPSKGVL FYGPPGCGKT LLAKAIANEC QANFISIKGP ELLTMWFGES EANVREIFDK ARQAAPCVLF FDELDSIAKA RGGNIGDGGG AADRVINQIL TEMDGMSTKK NVFIIGATNR PDIIDPAILR PGRLDQLIYI PLPDEKSRVA ILKANLRKSP VAKDVDLEFL AKMTNGFSGA DLTEICQRAC KLAIRESIES EIRRERERQT NPSAMEVEED DPVPEIRRDH FEEAMRFARR SVSDNDIRKY EMFAQTLQQS RGFGSFRFPS GNQGGAGPSQ GSGGGTGGSV YTEDNDDDLY G (507-806 aa encoded by BC007562)
靶标信息
The protein encoded by this gene is a member of a family that includes putative ATP-binding proteins involved in vesicle transport and fusion, 26S proteasome function, and assembly of peroxisomes. This protein, as a structural protein, is associated with clathrin, and heat-shock protein Hsc70, to form a complex. It has been implicated in a number of cellular events that are regulated during mitosis, including homotypic membrane fusion, spindle pole body function, and ubiquitin-dependent protein degradation.
仅用于科研。不用于诊断过程。未经明确授权不得转售。
生物信息学
蛋白别名: 15S Mg(2+)-ATPase p97 subunit; AAA ATPase p97; homolog of yeast cdc48; Inv protein; or HEL-S-70; p97 atpase; TER ATPase; Transitional endoplasmic reticulum ATPase; unnamed protein product; Valosin-containing protein; VCP
基因别名: 3110001E05; CDC48; FTDALS6; HEL-220; HEL-S-70; p97; p97/VCP; TERA; VCP
UniProt ID: (Human) P55072, (Mouse) Q01853
Entrez Gene ID: (Human) 7415, (Mouse) 269523